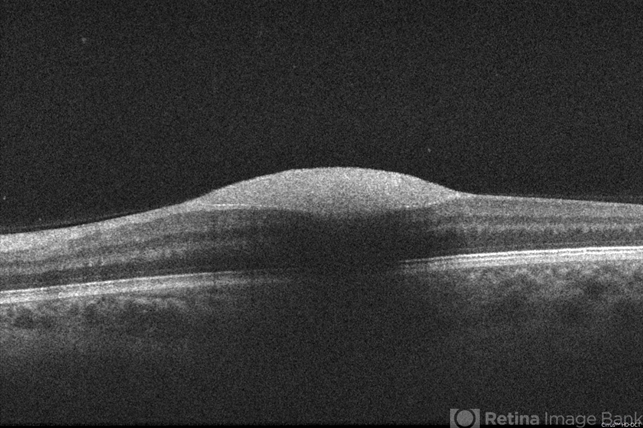
file

-
 By Allen Chiang, MD, FASRS
By Allen Chiang, MD, FASRS
Wills Eye Hospital Retina Service
Co-author(s): Allen Chiang, MD - Uploaded on Sep 20, 2012.
- Last modified by Allen Chiang, MD, FASRS on Sep 21, 2012.
- Rating
- Appears in
- Miscellaneous
- Condition/keywords
- preretinal hemorrhage
- Imaging device
-
Optical coherence tomography system
Zeiss Cirrus - Description
- 34-year old woman with preretinal hemorrhage in the macula, with dehemoglobinization occuring within the central portion of the hemorrhage while undergoing observation.

Initializing download.
Initializing download.







---thumb.jpg/image-square;max$79,0.ImageHandler)


